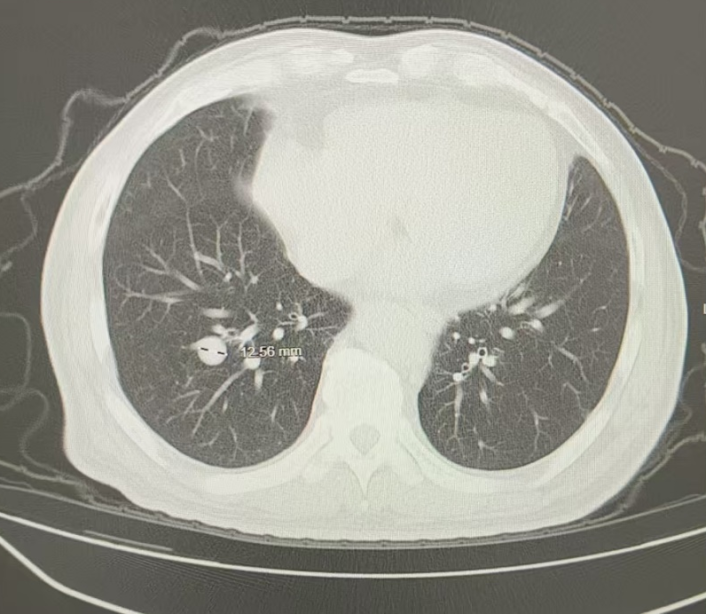
图片

肾例在握|培唑帕尼一线治疗肾癌术后复发伴远处肺转移患者可实现长期疾病控制

在肾癌
诊疗领域快速发展的背景下,“肾例在握”项目旨在构建一个开放且专业的学术交流平台,通过病例分享和专家点评
等形式,促进临床医生深入理解前沿治疗理念及指南规范,从而缩小临床进展与临床实践之间的差距,推动肾癌治疗领域的全面发展。
肾细胞癌
(RCC)是泌尿系统常见的恶性肿瘤之一,初诊时已发生远处转移或双侧发病的患者比例较高。随着靶向治疗的不断发展,以培唑帕尼
为代表的酪氨酸激酶抑制剂(TKI)已成为晚期RCC治疗的重要选择,其在不同临床场景中的应用价值也逐步拓展。为此,本期特邀宁波市中西医结合医院樊晓栋教授分享一例术后肺转移RCC患者经国产培唑帕尼治疗后获得长期缓解的诊治经验,并邀请福建医科大学附属协和医院李梦强教授点评,为优化晚期肾癌临床实践提供更多思路。

病例介绍
基本信息
患者男性,73岁
既往史
高血压
病史20余年,规律服用降压药物
现病史
一般查体
起病来,神志清,精神可,胃纳可,睡眠安,大小便无味,体重无明显改变
辅助检查

图1 患者基线胸部影像学图像(2024年4月16日)
ECT骨扫描未见骨转移;B超提示未见肝转移灶;头颅MRI提示未见脑转移
右肺穿刺病理:(肺结节穿刺标本)结合免疫组化及病史,符合肾透明细胞癌肺转移
免疫组化:TTF-1(-)、NapsinA(-)、CAIX(+)、PAX-8(+)

临床诊断
左肾透明细胞癌;肺部继发恶性肿瘤;国际转移性肾细胞癌数据库联盟(IMDC)低危组

治疗经过
2024年4月,开始接受培唑帕尼治疗(800mg,po,qd),每月复查随访。无明显药物副反应
2024年6月(治疗后2个月),复查胸部CT:两肺多发结节,转移灶首拟,对比2024.4.16老片,两肺结节有所减小,疗效评估为部分缓解(PR);无明显并发症;肿瘤指标等生化检查结果良好;无明显药物副作用

图2 患者治疗后2个月胸部影像学图像(2024年6月17日)
2024年9月(治疗后5个月),复查胸部CT:两肺多发结节,转移灶首拟,对比2024.6.17老片,两肺结节大致相仿,疗效评估为PR

图3 患者治疗后5个月胸部影像学图像(2024年9月23日)
2024年12月(治疗后8个月),复查胸部CT:两肺多发结节,转移灶首拟,对比2024.09.23老片,右下肺结节似略增大,疗效评估为疾病稳定(SD)

图4 患者治疗后8个月胸部影像学图像(2024年12月16日)
2025年3月(治疗后11个月),复查胸部CT:两肺多发结节,转移灶首拟,对比2024.12.16老片,右下肺结节略增大,疗效评估为SD
图5 患者治疗后11个月胸部影像学图像(2025年3月10日)
2025年4月(治疗后1年):无明显并发症;肿瘤指标等生化检查结果良好;无明显药物副作用
2025年5月(治疗后13个月),复查胸部CT:两肺多发结节,转移灶首拟,对比2025.3.10老片,右下肺结节似略饱满,疗效评估为疾病进展(PD),更换二线靶向联合免疫治疗方案

图6 患者治疗后13个月胸部影像学图像(2025年5月5日)

病例小结
本例RCC患者术后9年复发,出现肺部转移,IMDC低危,依据《中国临床肿瘤学会(CSCO)肾癌诊疗指南2025》规范化予以培唑帕尼靶向治疗[1]。治疗后2个月肺部转移病灶明显缩小,达到PR,并维持疾病稳定近1年。治疗期间无明显并发症,肿瘤指标等生化检查结果良好,无明显药物副作用。治疗后13个月因疾病进展更换二线靶向联合免疫治疗方案。该病例提示,培唑帕尼用于IMDC低危晚期RCC一线治疗,可快速缩瘤、有效控制病情,且安全性良好,能为患者带来稳定的疾病控制与良好的治疗耐受性,是晚期肾癌一线治疗中兼顾疗效与安全性的优选方案,也为后续序贯治疗创造了重要条件。
RCC是泌尿系统常见恶性肿瘤,术后远期复发转移的监测与规范化治疗是临床关注的重点。本例患者在左肾部分切除术后9年出现肺部转移,提示肾癌术后存在远期复发风险,即便度过常规5年随访期,仍应坚持长期病情监测,以实现复发后的早发现、早诊断,为后续有效治疗争取有利时机。
IMDC风险分层是晚期RCC治疗决策的核心依据,《CSCO肾癌诊疗指南(2025)》据此制定差异化治疗方案[1]。对于IMDC低危透明细胞RCC患者,以培唑帕尼为代表的TKI类药物是其标准一线治疗选择之一。培唑帕尼作为一种多靶点TKI,主要通过抑制血管内皮生长因子受体(VEGFR)、血小板衍生生长因子受体(PDGFR)等信号通路,发挥抗血管生成和抗肿瘤作用。COMPARZ研究及其中国亚组分析显示,培唑帕尼在客观缓解率(ORR)和早期缩瘤方面表现良好,且中国人群的无进展生存期(PFS)和ORR数据优于全球人群,为其临床应用提供了坚实循证依据[2,3]。本例患者接受培唑帕尼800mg标准剂量治疗后,2个月即达PR,肺部转移病灶明显缩小,并在随后近一年内持续维持肿瘤缓解与疾病稳定状态,直至13个月因疾病进展换用二线治疗。这一长期疗效数据印证了培唑帕尼在真实世界中的快速起效与持久控瘤能力。
此外,本例患者在全程13个月标准剂量治疗中,未见明显药物副作用及并发症,肿瘤指标与生化检查持续保持良好。这一安全性表现对老年患者尤为关键:良好的治疗耐受性不仅保障了生活质量与治疗依从性,确保了治疗强度与疗效的最大化,也使患者在疾病进展时仍保有理想体能状态,为后续二线靶向联合免疫治疗的顺利实施创造了有利条件。
综上所述,本病例为临床实践提供了三点核心启示:第一,肾癌术后需建立长期随访意识,警惕远期复发风险;第二,复发转移后应及时完成病理、分期与风险评估,以指导精准治疗;第三,一线治疗需兼顾短期缩瘤与长期布局,优先选用疗效确切、安全性可控的药物,为多线序贯治疗创造条件。这一策略是实现疾病长期控制、优化全程治疗格局的重要路径,有助于最终实现晚期RCC患者的生存获益最大化。
李梦强 教授
福建医科大学附属协和医院
医学博士,主任医师,博士生导师
福建医科大学附属协和医院泌尿外科行政副主任
中华医学会泌尿外科分会青年委员
福建省医学会泌尿外科分会委员会秘书
福建省医学会泌尿外科分会委员
以第一或通讯作者发表SCl论文二十多篇
樊晓栋 教授
宁波市中西医结合医院
宁波市中西医结合医院 肾脏外科 副主任医师
肾癌、尿路上皮癌的微创手术治疗及晚期肿瘤患者的精准治疗及全程管理
发表SCI及国内核心期刊论文10余篇
省级课题1项
参考文献
[1] 中国临床肿瘤学会指南工作委员会. 中国临床肿瘤学会(CSCO)肾癌诊疗指南2025[M]. 北京: 人民卫生出版社, 2025.
[2] Motzer RJ, et al. N Engl J Med. 2013 Aug 22;369(8):722-31.
[3] Sheng X,et al. BMC Cancer. 2020 Mar 14;20(1):219.
//
1.肾例在握 | 晚期转移性肾癌患者经培唑帕尼治疗后成功接受减瘤术,迎来生存新曙光
医脉通是专业的在线医生平台,“感知世界医学脉搏,助力中国临床决策”是平台的使命。医脉通旗下拥有「临床指南」「用药参考」「医学文献王」「医知源」「e研通」「e脉播」等系列产品,全面满足医学工作者临床决策、获取新知及提升科研效率等方面的需求。仅供HCP观看。